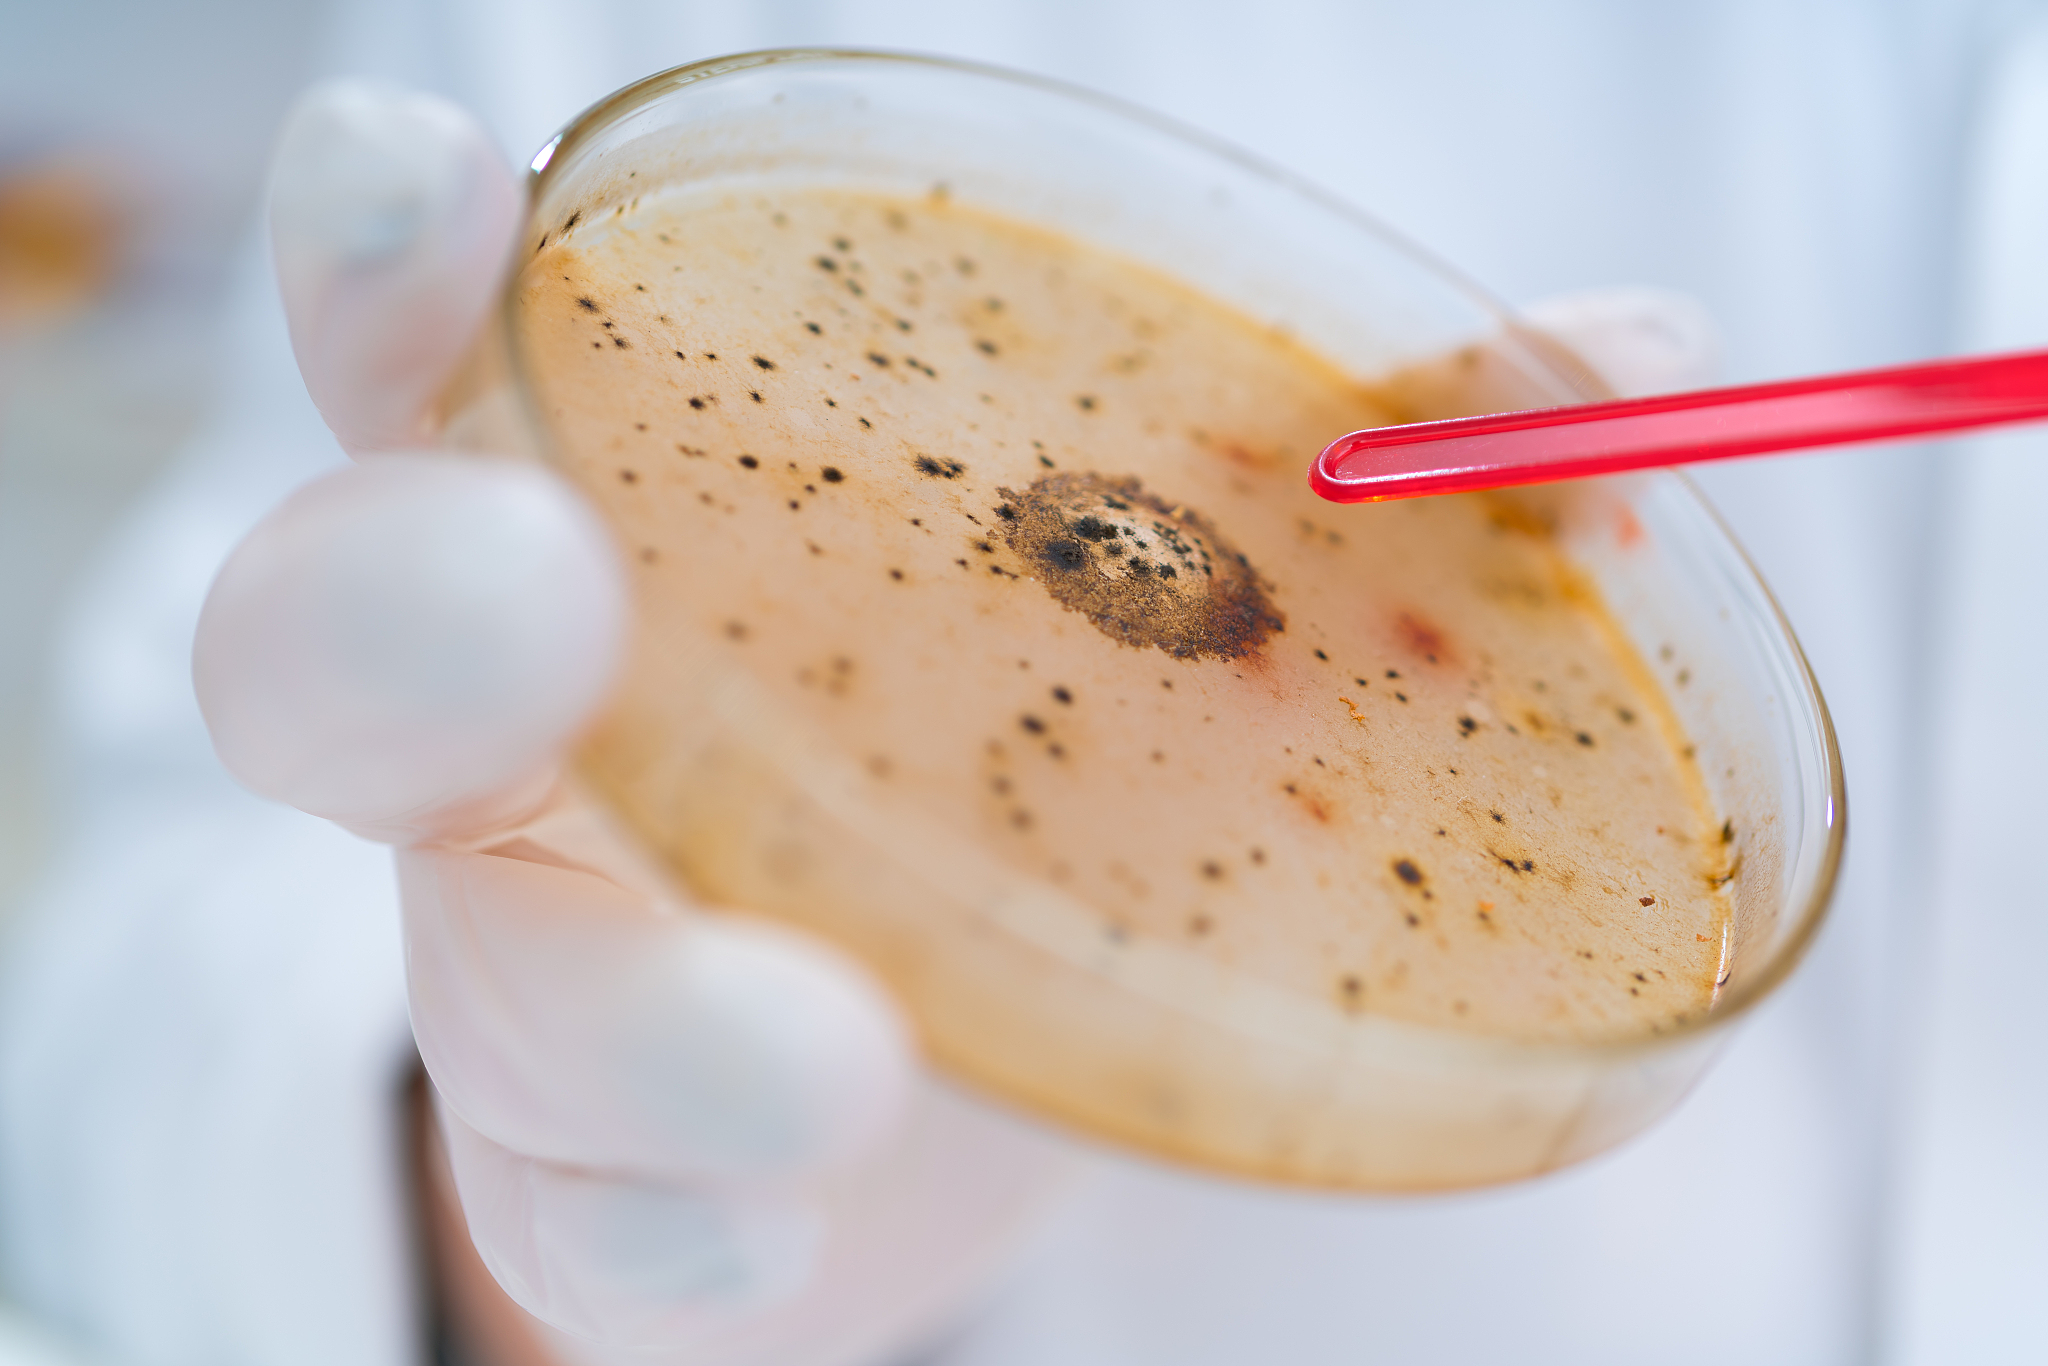
华东理工大学食品质量与安全专业怎么样

华东理工大学食品质量与安全专业怎么样
华东理工大学食品质量与安全专业的优势和发展前景
华东理工大学食品质量与安全专业是一门涵盖食品科学、生物学、化学等多个领域的专业,旨在培养具备食品质量与安全知识和技能的高素质人才。那么,华东理工大学食品质量与安全专业究竟怎么样呢?它的优势和发展前景又是如何的呢?
华东理工大学食品质量与安全专业的课程设置涵盖了食品生产、加工、检测、质量控制等多个方面,学生可以在学习中全面掌握食品质量与安全的相关知识和技能。此外,华东理工大学拥有一流的师资力量和先进的实验设备,学生可以在这里得到优质的教育和培训,为未来的职业发展打下坚实的基础。
随着人们对食品质量与安全的关注度越来越高,食品质量与安全专业的发展前景也越来越广阔。毕业生可以在食品生产、加工、检测、质量控制等相关领域就业,同时还可以从事食品安全监管、食品咨询等工作。此外,随着互联网技术的发展,食品电商、食品配送等新兴行业也对食品质量与安全专业的毕业生提供了更多就业机会。
总之,华东理工大学食品质量与安全专业具有广阔的发展前景和优秀的教育资源,是一门非常值得学习和选择的专业。希望有更多的学生能够选择这门专业,并在未来的职业生涯中为保障食品质量与安全做出自己的贡献。
####################
华东理工大学食品质量与安全专业
华东理工大学
发散性思维:食品安全问题的挑战与应对
随着人们生活水平的提高,对于食品质量与安全的要求也越来越高。然而,随之而来的是食品安全问题的频发,这给消费者的健康和安全带来了巨大的威胁。那么,面对食品安全问题的挑战,我们应该如何应对呢?
首先,加强监管是解决食品安全问题的关键。政府应该加强对食品生产、加工、销售等环节的监管力度,建立完善的食品安全管理制度,对于违规企业和个人要严格处罚,以此来保障消费者的权益和健康。
其次,加强科技创新也是解决食品安全问题的重要途径。食品质量与安全专业的毕业生可以在食品生产、加工、检测等领域应用新技术,提高食品质量与安全的水平。同时,政府和企业也应该加大对食品科技创新的投入,提高食品质量与安全的技术含量和水平。
最后,加强公众教育也是解决食品安全问题的重要手段。消费者应该提高食品安全意识,了解食品质量与安全的相关知识,学会选择安全的食品。同时,政府和企业也应该加强对公众的食品安全宣传和教育,提高消费者的食品安全意识和素质。
总之,食品安全问题是一个复杂的系统工程,需要政府、企业、专业人才和公众的共同努力来解决。而华东理工大学食品质量与安全专业的毕业生可以在这个领域中发挥重要作用,为保障食品质量与安全做出自己的贡献
原文地址: https://www.cveoy.top/t/topic/ds20 著作权归作者所有。请勿转载和采集!